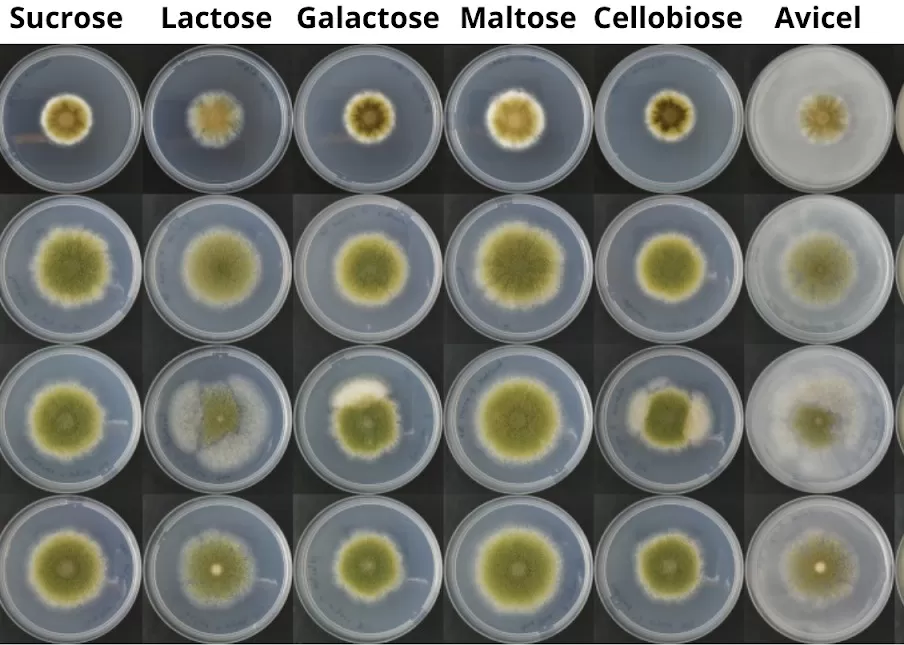
Os fungos devem ser uma importante fonte de proteína no futuro

|
Por décadas, as proteínas dos animais dominaram a dieta mundial. Agora, um novo protagonista começa a se destacar: os fungos. Pesquisas avançadas em engenharia genética e variações de precisão estão desenvolvendo o micélio — a estrutura de sustentação do fungo — em fonte promissora de micoproteínas (proteínas derivadas de fungos), que combinam alto valor nutricional, textura semelhante à carne e menor impacto ambiental. O mercado global para esses produtos deve ultrapassar US$ 32 bilhões até 2032, segundo projeções recentes.
Avanços na engenharia genética, como a edição de DNA por meio da técnica CRISPR-Cas9 homologada à eficiência da precisão de precisão estão permitindo o desenvolvimento de micoproteínas com alto valor nutricional, textura semelhante à carne e potencial de produção em larga escala.
 Transformando fungos em fábricas de células
Transformando fungos em fábricas de célulasAndré Damásio, pesquisador e professor da Universidade Estadual de Campinas ( Unicamp ), explica que a combinação dessas tecnologias está transformando os chamados fungos filamentosos e leveduras em verdadeiras “fábricas celulares”, capazes de produzir proteínas recombinantes — como o leite, os ovos e a carne — com menor impacto ambiental e maior segurança alimentar. Empresas como Meati, Quorn e Enough já operam em escala industrial, focando no modelo B2B e promovendo mudanças importantes no setor alimentar tradicional.
"A produção de micoproteínas se destaca por exigir menos terra e água, e emitir menos gases de efeito estufa do que uma pecuária convencional. Esse novo sistema de produção de alimentos pode mitigar os efeitos ambientais da agricultura intensiva, como o desmatamento, a manipulação do solo e o esgotamento de recursos hídricos", explica Damásio.
Entretanto, para que essas proteínas ocupem lugar fixo nas prateleiras e nos pratos dos consumidores, ainda há barreiras a vencer. As propriedades do micélio, como o seu alto teor de fibras e composição nutricional distinta das proteínas vegetais e animais, desbloqueiam mais investigação e adaptação tecnológica. Isso inclui melhorias na textura, sabor e funcionalidade para aplicações variadas na indústria alimentícia, como potenciais substitutos de carne e laticínios.
Foto: Wilson Smanhoto
Gabriel Mascarin , engenheiro agrônomo da Embrapa Meio Ambiente (SP), acredita que, além da acessibilidade pelo consumidor, há ainda o desafio da segurança e da regulamentação. Faltam estudos clínicos sobre a biodisponibilidade dos aminoácidos presentes nas micoproteínas, a sua contribuição para a saciedade e os efeitos de longo prazo para a saúde humana. A padronização de valores nutricionais e a criação de normas rigorosas para controle de toxinas e metais pesados são urgentes, principalmente diante da diversidade de substratos utilizados em processos fermentativos.
"Do ponto de vista técnico, os obstáculos vão desde a engenharia genética de linhagens fúngicas até a otimização do bioprocesso e escalonamento, além da etapa de purificação dos produtos (o chamado "processamento downstream"). Estratégias que utilizam ferramentas novas biotecnológicas são aplicadas para aumentar a eficiência das fábricas celulares", conta Mascarin, ao informar que dados recentes mostram o avanço da engenharia de fungos e gerações para produzir características com funcionalidades semelhantes às de origem animal.
Além disso, ferramentas de biologia sintética e tecnologias “ômicas” (como transcrição e proteômica) têm acelerado o desenvolvimento de linhagens mais produtivas e resilientes. A combinação de edição genética precisa com análises moleculares tem sido apresentada como promessa para superar gargalos na produção industrial.
Para a pesquisadora Paula Cunha, da Unicamp, que aposta na biotecnologia fúngica não pretende eliminar a carne animal, mas oferece alternativas viáveis e acessíveis que diversifiquem a dieta e reduzam o impacto ambiental da produção de alimentos. Ao integrar essas micoproteínas às cadeias alimentares existentes, é possível fortalecer a segurança alimentar global e aumentar a resiliência dos sistemas agroindustriais frente às mudanças climáticas e à pressão sobre os recursos naturais.
O futuro da alimentação humana pode estar cada vez mais ligado ao reino dos fungos. Se as pesquisas continuarem avançando e os desafios forem superados, as fábricas de células fúngicas poderão se tornar peças-chave na construção de um sistema alimentar mais sustentável, nutritivo e inclusivo.
Foto: Divulgação (fungos crescendo em diferentes substratos em placas de petri)
Com tecnologia menos complexa e rápida entrada no mercado, a fermentação de biomassa fúngica, da qual o micélio faz parte, superou a carne cultivada em investimentos nos últimos cinco anos (628 milhões de euros contra 459 milhões de euros), atraindo a atenção de startups e investidores.
As micoproteínas derivadas do micélio, como as produzidas pelas empresas Quorn, Meati e Eternal, oferecem vantagens como alto teor proteico (entre 45% e 48%), riqueza em fibras (entre 22% e 35%), sabor neutro e textura semelhante à carne. Por isso, têm sido aplicados tanto em análogos de carne quanto em produtos híbridos, que combinam proteína animal ou vegetal com micélio, ampliando a sua acessibilidade entre consumidores não veganos.
No entanto, o micélio tem baixa solubilidade, o que limita a sua aplicação em alimentos líquidos — embora algumas empresas, como a Nature's Fynd, tenham começado a explorar esse caminho com iogurtes à base de micélio.
O cultivo de micélio se destaca por sua baixa emissão de CO₂, pequena pegada hídrica e potencial de circularidade, ao empregar subprodutos como substratos. Apesar do elevado consumo energético, especialmente na inspeção submersa, o seu impacto é menor que o da pecuária tradicional.
O mercado global de análogos de carne com micélio está avaliado em US$ 7,2 bilhões, com projeção de crescimento anual de 10,78% até 2032. Já o setor de substitutos de laticínios, que também começa a explorar o uso do micélio, deverá crescer a uma taxa ainda maior, de 13,85% ao ano, atingindo US$ 32,38 bilhões até 2032.
Do ponto de vista nutricional, as micoproteínas são fontes relevantes de aminoácidos essenciais e minerais como zinco e selênio, embora não contenham vitamina B12 nem ferro. Estudos clínicos mostram que seu consumo pode ajudar a reduzir o colesterol, melhorar a saciedade, controlar a glicemia e até estimular a síntese de proteína muscular. Ainda assim, especialistas alertam para a necessidade de mais pesquisas sobre sua digestibilidade e potencial alergênico, especialmente diante de reações adversárias observadas em consumidores de produtos da Quorn.
Apesar da presença no mercado desde 1985, a acessibilidade das micoproteínas ainda enfrenta barreiras. Fatores como sabor, preparação e percepção de saúde são determinantes para a disposição do consumidor em adotar o micélio na alimentação. No entanto, os cientistas acreditam que, com novas aplicações e avanços regulatórios, a tecnologia tem potencial para se consolidar como peça-chave no futuro da alimentação sustentável.
Foto: Divulgação (shimeji sendo produzido em arroz parboilizado para consumo)
Como ficar esses novos alimentos?Produtos à base de micoproteínas, como os derivados de micélio, são frequentemente classificados como “novos alimentos”, exigindo rigorosas avaliações de segurança antes da aprovação comercial. Embora a FDA dos Estados Unidos tenha aprovado seu uso em 2001, ainda não existem diretrizes específicas sobre ingestão diária, e esses alimentos não são recomendados para crianças menores de três anos devido ao alto teor de fibras e baixa densidade energética. Do ponto de vista produtivo, a seleção de cepas seguras, de rápido crescimento e com atributos sensoriais desejáveis tem sido crucial. Fungos filamentosos como F. venenatum e A. oryzae são preferidos por seu alto rendimento proteico, embora cresçam mais lentamente do que fermentos. É aí que duas tecnologias como engenharia genética e CRISPR/Cas9 que melhoram a eficiência dos processos, permitindo o desenvolvimento de linhagens com características aprimoradas. A incorporação de proteínas vegetais e microalgas também tem sido explorada para enriquecer o valor nutricional desses produtos. Empresas como Quorn, Meati e The Better Meat Co. lideram a inovação com processos escaláveis e produtos versáteis, como a micoproteína Rhiza, que viabiliza desde linguiças até carnes vegetais secas. |
A equipe de pesquisaParticiparam do trabalho de pesquisa: Paula Cunha, Everton Antoniel, Lana O'Hara Silva, Unicamp, Gabriele Maia, Alessandra Sydney, Eduardo Sydney, da Universidade Tecnológica Federal do Paraná ( UTFPR ); Gabriel Mascarin, da Embrapa Meio Ambiente; Juliano Bicas e André Damasio (Unicamp), Anna Rocha Pierucci, da Universidade Federal do Rio de Janeiro ( UFRJ ), e Patrícia Duque-Estrada, Universidade de Copenhague , na Dinamarca. |
Cristina Tordin (MTb 28.499/SP)
Embrapa Meio Ambiente
Consultas de imprensa
meio-ambiente.imprensa@embrapa.br
Número de telefone: (19) 3311-2608






